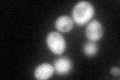
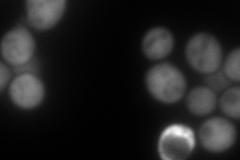
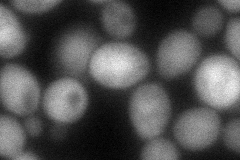
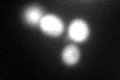

View description
NADPH-dependent aldo-keto reductase, reduces multiple substrates including 2-methylbutyraldehyde and D,L-glyceraldehyde, expression is induced by osmotic and oxidative stress; functionally redundant with other aldo-keto reductases
Localization:
Intensity:
Fold change:
Significance:
-
C’ GFP library in SD
cytosol59.24 -
N' NOP1pr-GFP in SD

cytosol353.072 -
N' TEF2pr-mCherry in SD
cytosol343.096 -
N' NATIVEpr-GFP in SD

cytosol47.5751 -
N' TEF2pr-VC and Cyto-VN in SD
cytosol83.9765 -
C’ GFP library in SD+DTT
cytosol92.231.55Yes -
C’ GFP library in SD+H2O2

cytosol97.451.64Yes -
C’ GFP library in Starvation Media

nucleusN/AN/AYes -
C’ GFP library on the background of Pup2-DaMP

cytosol -
C’ GFP library on the background of CCT mutant

cytosol60.08721.01414No
